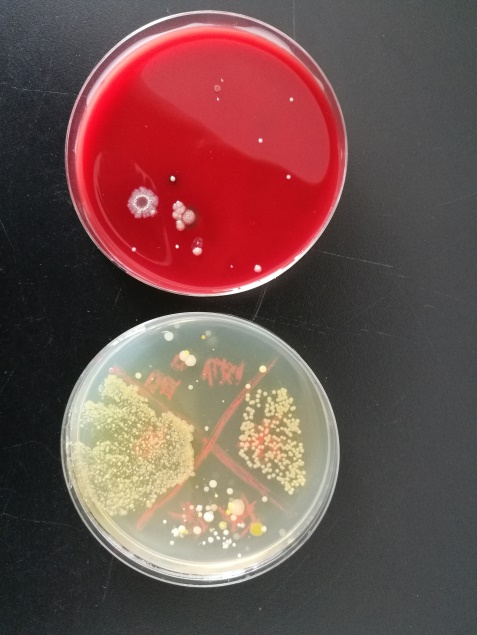

形态学实验室简介
1 实验室概况
形态学实验室包括正常人体解剖学与组织胚胎学实验室、病理学实验室、病原生物学与免疫学实验室3个实验室及人体解剖与组织胚胎标本陈列室、病理标本陈列室。
2 实验室师资队伍
形态学实验室现有专职教师9人,兼职教师16人,平均年龄低于40岁,是一支年轻具有活力的教师队伍。其中博士6人,硕士17人,学士2人;教授2人,副教授7人,讲师8人,实验师6人,助理实验师2人。具有硕博士学位的专兼职教师占92%,校级骨干教师3名,确保相关专业实验教学一线由优秀教师执教。

3 承担教学情况
形态学实验室承担全院各类专业的《正常人体解剖学》、《局部解剖学》、《护理应用解剖学》、《解剖生理学》、《组织胚胎学》、《病理学》、《免疫学基础与病原生物学》、《微生物学》、《微生物学与免疫学》、《医学微生物学与免疫学实验技术》等十余门课程的实验教学工作。在实验教学工作中坚持以学生为中心的教学理念,积极进行教学改革与探索,开发建设虚拟仿真教学平台,丰富了本科实验教学资源。
4 实验室成员主持科研项目情况
本实验室教师主持科研项目共计17项,其中国家自然科学基金3项,省级科研项目6项,厅级科研项目8项。实验室作为科研实验平台承担各级各类科研项目20余项。实验室教师发表的教学、科研论文70余篇,出版的教材及专著7部。曾荣获省级教学成果奖二等奖;云南省卫生科技成果奖三等奖;校级教学成果一等奖。
主持科研项目情况表
|
项 目 名 称 |
类 型 |
主持人 |
年度 |
资助金额(万元) |
|
基于肠道微环境探讨四君子汤通过“扶正”干预哮喘的分子机理研究 |
国家自然科学基金 |
陈静 |
2019 |
34 |
|
国家自然科学基金 |
陈静 |
2017 |
36 |
|
|
3种黄连属濒危植物内生放线菌多样性及其抗菌消炎活性初探 |
国家自然科学基金 |
田守征 |
2017 |
19 |
|
基于VEGF-Ang-Notch通路及miRNA探究调和气血法干预COPD肺血管重构的分子机制 |
云南省科技计划联合专项 |
陈静 |
2018 |
10 |
|
柚皮素对慢性骨髓炎成骨细胞自噬信号的作用及机制研究 |
云南省科技计划联合专项 |
陈学秋 |
2018 |
10 |
|
四君子汤调节肠道微环境干预哮喘的分子机理研究 |
云南省科技计划联合专项 |
陈静 |
2017 |
10 |
|
滇重楼根茎内生放线菌生物多样性研究 |
云南省科技计划青年项目 |
田守征 |
2016 |
6 |
|
滇重楼内生菌分离纯化及微生物转化的研究 |
云南省科技计划青年项目 |
朱晓松 |
2016 |
6 |
|
化痰祛瘀法调节TGF-β1/Smads信号通路干预大鼠哮喘气道重塑作用的分子机制研究 |
云南省应用基础研究项目 |
陈静 |
2014 |
10 |
|
膈下逐瘀汤对非酒精性脂肪肝大鼠肝自噬相关蛋白Beclin1 与LC3-II 表达的影响 |
云南省教育厅科研项目 |
谭丽萍 |
2018 |
4 |
|
电针对有氧运动预处理后全脑缺血大鼠再灌注损伤干预作用的研究 |
云南省教育厅科研项目 |
褚鑫 |
2017 |
2 |
|
两种经验方干预COPD大鼠气道三种常见细菌的对比实验研究 |
云南省教育厅科研项目 |
彭静 |
2016 |
2 |
|
玉屏风散合四物汤对COPD大鼠氧化应激及气道炎症因子IL-8的影响 |
云南省教育厅科研项目 |
田守征 |
2015 |
1 |
|
滇重楼内生菌分离及微生物转化的研究 |
云南省教育厅科研项目 |
朱晓松 |
2015 |
1 |
|
玉屏风散加味方对COPD大鼠气道流感嗜血杆菌负荷的影响 |
云南白药研究基金 |
彭静 |
2014 |
1 |
|
TGF-β1、MMP-9在哮喘大鼠气道重建模型中的表达及丹参的干预作用研究 |
云南省教育厅科研项目 |
陈静 |
2013 |
1 |
|
人体面部蠕形螨的致病性与皮肤菌群的相关性研究 |
云南省教育厅科研项目 |
陈静 |
2011 |
1 |